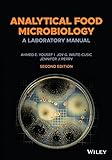
Amazon cover image

| Item type | Current library | Call number | Materials specified | Status | Date due | Barcode | |
|---|---|---|---|---|---|---|---|
| Books | VIVEKANANDA LIBRARY Vivekananda Library | 664.07 Y88A(2) (Browse shelf(Opens below)) | Available | 444176 |
There are no comments on this title.
Log in to your account to post a comment.